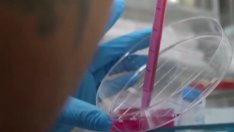
Що е то: Синтетичен ембрион, без използване на сперма и яйцеклетка?

Инфографика: pixotab.com
В света на технологичния напредък мобилните телефони се превърнаха в неделима част от ежедневието ни. Независимо дали се използват за комуникация, развлечение или работа, тези устройства се превърнаха в незаменим аксесоар за мнозина. Въпреки това, последни изследвания подчертават потенциалната връзка между интензивното използване на мобилните телефони и качеството на мъжката сперма, създавайки нови притеснения за мъжкото репродуктивно здраве.
Броят на мъжките сперматозоиди е намалял с повече от 50% в световен мащаб през последните 50 години, карайки изследователите да се мъчат да разберат защо. Може ли да е замърсяване, токсини в нашата храна и вода, увеличаване на затлъстяването и хронични заболявания или дори винаги присъстващият мобилен телефон?
Изследователи от Женевския университет (UNIGE) и Швейцарския институт за тропическо и обществено здраве (Swiss TPH) проведоха обширно проучване, което се фокусира върху връзката между използването на мобилни телефони и параметрите на спермата. Резултатите, които бяха получени са публикувани в Fertstert се оказаха от значение и вдъхновиха нови размисли за влиянието на технологията върху нашето здраве, пише pixotab.com.
Изследването включваше данни от 2886 мъже на възраст между 18 и 22 години, събрани в периода между 2005 и 2018 година. Участниците предоставиха информация за своите навици и честота на използване на мобилни телефони. Те откриха, че концентрацията на сперматозоиди е значително по-висока в групата на мъжете, които не използват телефона си повече от веднъж седмично (56,5 милиона на милилитър), в сравнение с мъжете, които използват телефона си повече от 20 пъти на ден (44,5 милиона на милилитър). Разликата е от 21%. Това със сигурност е изненадващо и тревожно откритие.
Мъжете можеха да избират дали да носят мобилния си телефон в джоб на панталон, джоб на гърдите, носач на колан или другаде, но над 85% от тях поставят телефона си в джоба на панталоните си, когато не го използват. Учените установяват, че няма съществени разлики при носенето на телефон, когато не се използва.
Мъжете с концентрация на сперматозоиди под 15 милиона на милилитър могат да се сблъскат с трудности при зачеването в рамките на една година, според Световната здравна организация (СЗО).
Интересно е, че връзката между мобилните телефони и качеството на спермата беше по-силно изразена в началния период на изследването (2005-2007 година), но намаляваше с времето. Някои учени предполагат, че това може да бъде свързано с прехода от 2G към 3G и след това към 4G мрежите, които със сигурност носят изменения в телефонното предаване и въздействие върху организма.
Важно е да се отбележи, че въпреки новите открития, съществуват и други фактори, които могат да влияят на качеството на спермата и мъжкото репродуктивно здраве. Някои от тях са свързани с околната среда и начина на живот. Това означава, че не можем да припишем цялата отговорност върху мобилните телефони, но определено е необходимо да продължим изследванията в тази насока.
Предстоящи проучвания, предвидени за тази година, ще се стремят да дадат по-подробно обяснение за механизмите, през които мобилните телефони влияят върху качеството на спермата. Също така, изследователите се надяват, че по-голям брой участници ще се включат в тези проучвания, за да се получи по-надеждна информация.
Връзката между мобилните телефони и качеството на спермата е тема, която изисква допълнително проучване и разглеждане. Въпреки че все още имаме много въпроси и неясноти, този вид научни изследвания ни подсказва, че умереността в използването на мобилните телефони може да е ключът към поддържане на мъжкото репродуктивно здраве.

Почина оперната прима Стефка Евстатиева
Почина оперната прима Стефка Евстатиева  Монтираха коледната елха на "Рокфелер център" в Ню Йорк (СНИМКИ)
Монтираха коледната елха на "Рокфелер център" в Ню Йорк (СНИМКИ)  "Рома" излезе начело в Серия "А" след победа над "Удинезе"
"Рома" излезе начело в Серия "А" след победа над "Удинезе"  Изобилие и късмет за три зодии на 10 ноември
Изобилие и късмет за три зодии на 10 ноември 
 MeerKAT засече радиосигнал от междузвездната комета 3I/ATLAS
MeerKAT засече радиосигнал от междузвездната комета 3I/ATLAS  Неочаквано откритие: Момиче намери на плажа следи от гигант на 200 млн. години
Неочаквано откритие: Момиче намери на плажа следи от гигант на 200 млн. години  Канадски учен твърди: Извънземни се крият на Луната и шпионират Земята
Канадски учен твърди: Извънземни се крият на Луната и шпионират Земята  Учени откриха „блуждаеща“ планета, която поглъща 6 млрд. тона вещества в секунда
Учени откриха „блуждаеща“ планета, която поглъща 6 млрд. тона вещества в секунда 
 В Лудогорец публично назоваха големия виновник за невижданата криза
В Лудогорец публично назоваха големия виновник за невижданата криза  ЦСКА доминира над Левски във Вечното време от четвърт век
ЦСКА доминира над Левски във Вечното време от четвърт век  Цветомир Найденов „захапа“ здраво треньора на Левски
Цветомир Найденов „захапа“ здраво треньора на Левски  Треньорска лекция! Янев изнесе открит урок на ученика Веласкес
Треньорска лекция! Янев изнесе открит урок на ученика Веласкес 
 Дневен хороскоп за 10 ноември, понеделник
Дневен хороскоп за 10 ноември, понеделник  Седмичен хороскоп за 10 – 16 ноември
Седмичен хороскоп за 10 – 16 ноември  Седмична таро прогноза за 10 – 16 ноември
Седмична таро прогноза за 10 – 16 ноември  Трапезата на Свети Мина
Трапезата на Свети Мина 
 Епидемия от самота и отсъствие на принадлежност мъчи съвременния човек
Епидемия от самота и отсъствие на принадлежност мъчи съвременния човек  Приемът на мелатонин се свърза с повишен риск от сърдечна недостатъчност
Приемът на мелатонин се свърза с повишен риск от сърдечна недостатъчност  Доц. д-р Красимира Христова с международно признание на световния форум по хипертония в Китай
Доц. д-р Красимира Христова с международно признание на световния форум по хипертония в Китай  Мобилни екипи на Националния център за психосоматика осигуряват психологична грижа за пациенти с тежки заболявания в София
Мобилни екипи на Националния център за психосоматика осигуряват психологична грижа за пациенти с тежки заболявания в София 
 дава под наем, Двустаен апартамент, 50 m2 София, Белите Брези, 550 EUR
дава под наем, Двустаен апартамент, 50 m2 София, Белите Брези, 550 EUR  дава под наем, Тристаен апартамент, 100 m2 София, Слатина, 818.07 EUR
дава под наем, Тристаен апартамент, 100 m2 София, Слатина, 818.07 EUR  дава под наем, Тристаен апартамент, 100 m2 София, Гео Милев, 818.07 EUR
дава под наем, Тристаен апартамент, 100 m2 София, Гео Милев, 818.07 EUR  дава под наем, Тристаен апартамент, 125 m2 София, Манастирски Ливади, 1400 EUR
дава под наем, Тристаен апартамент, 125 m2 София, Манастирски Ливади, 1400 EUR 











 Новият бум на ядрената енергия в САЩ започва със стар проблем
Новият бум на ядрената енергия в САЩ започва със стар проблем  Почина оперната прима Стефка Евстатиева
Почина оперната прима Стефка Евстатиева  Българският AI стартъп, който преобразява земеделието със синтетични данни
Българският AI стартъп, който преобразява земеделието със синтетични данни  Големи, но проблемни: Пет V8 двигателя с кратък ресурс
Големи, но проблемни: Пет V8 двигателя с кратък ресурс  Изкуството на ухажването: 5 старомодни мъжки поведения, които винаги ще са актуални
Изкуството на ухажването: 5 старомодни мъжки поведения, които винаги ще са актуални  Венера в Скорпион - какво очаква зодиите?
Венера в Скорпион - какво очаква зодиите?
Коментари